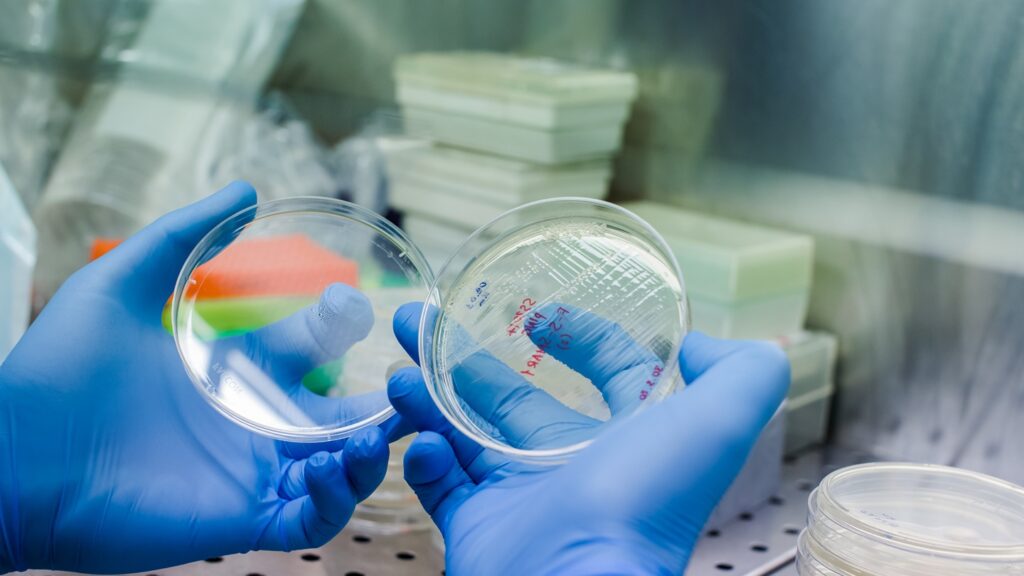
Growing,Bacteria,To,Create,Car,Therapy,-,The,Novel,Method

US-based biotechnology company Rallybio has entered a definitive agreement to acquire Candid Therapeutics through a merger transaction.
The capital will be used to progress Candid’s T-cell engager portfolio through key milestones. Credit: Vshivkova / Shutterstock.com.
Subscribe to our email newsletter
Following completion, the combined entity will operate as Candid Therapeutics and list on Nasdaq under the “CDRX” ticker symbol.
As part of the merger, Candid has secured more than $505m in gross proceeds from a concurrent private financing round.
The round is supported by institutional investors such as RA Capital Management; Venrock Healthcare Capital Partners; accounts advised by entities such as Cormorant Asset Management, Foresite Capital, and Janus Henderson Investors; additional mutual funds and others.
The combined cash balance at closing is projected to fund operations through 2030.
The capital will be used to progress Candid’s T-cell engager (TCE) portfolio through key milestones. This includes planned initiation and clinical data readouts from Phase II studies for cizutamig, a TCE targeting B-cell maturation antigen (BCMA), in myasthenia gravis and interstitial lung disease.
Both companies’ boards have unanimously approved the transaction, which is set to close by mid-2026, subject to customary closing conditions, including shareholder approval and regulatory clearances.
After the transaction is finalised, it is anticipated that the existing equityholders of Rallybio will hold 3.65% of the new merged entity. Meanwhile, the equityholders of Candid, including those investors involved in the financing, are projected to own around 96.35% of the company.
The combined company expects pro-forma cash of around $700m at closing. Candid chairman, president and CEO Dr Ken Song will lead the new entity.
Rallybio co-founder and CEO Dr Stephen Uden said: “We are pleased to announce this transaction, which we believe represents a compelling opportunity for Rallybio stockholders to participate in the future value creation of a well-capitalised, clinical-stage company with a differentiated and broad portfolio of TCE drug candidates.
“Candid’s clinical data in myasthenia gravis and across its autoimmune pipeline, combined with the strong endorsement of leading healthcare investors, further substantiates the merit of this transaction.”
In April 2024, Rallybio announced a collaboration with Johnson & Johnson to advance complementary therapeutic solutions for foetal and neonatal alloimmune thrombocytopenia (FNAIT).
 Advertise With UsAdvertise on our extensive network of industry websites and newsletters.
Advertise With UsAdvertise on our extensive network of industry websites and newsletters.
 Get the PBR newsletterSign up to our free email to get all the latest PBR
news.
Get the PBR newsletterSign up to our free email to get all the latest PBR
news.

